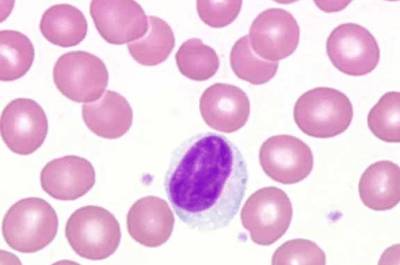

Содержание
Лимфоциты являются особыми видами клеток лейкоцитов, чья задача в организме заключается в осуществлении защитных функций. Именно количественный состав лейкоцитов указывает на то, какой у человека иммунитет и насколько он подвержен пагубному воздействию патогенной микрофлоры. Любые колебания показателей свидетельствует о наличии патологий, причину которых следует определить максимально быстро. При каких ситуациях могут быть повышены лимфоциты в крови, о чем это свидетельствует и насколько опасно для жизни, рассмотрим далее.
Какие показатели считать повышенными?
Лимфоцит формируется из стволовой клетки, когда это необходимо организму. Существует несколько их видов: B, T, Nk. Лимфоциты группы B способны вырабатывать иммуноглобулины – особые клетки, наличие которых объясняет иммунитет к вирусным и инфекционным заражениям. Т-лимфоциты способны ликвидировать чужеродные патогенные клетки, которые уже проникли в клетки организма, вступая с ними в контр-реакцию.
Лимфоциты последней группы помогают контролировать процесс отмирания и деления клеток, поскольку способны противостоять формированию раковых опухолей.

- новорожденные – 15-35%;
- дети до 1,5 лет – 45-65%;
- дети до 12 лет – 40-55%;
- подростки 12-16 лет – 40-50%;
- от 16 до 35 лет – 35-45%;
- старше 35 лет – 30-40%.
Данные показатели являются относительными, то есть учитывается их процентное соотношение к общему объему крови.
Обычно в анализе крови используются именно эти данные, отображающие количественный состав белых клеток. В случае, когда есть необходимость уточнения, используют абсолютные значения, отображающие абсолютное содержание иммунных клеток в 1 литре крови, которые также отличаются по возрастам:
- дети до 6 лет – 0,8-9*109 клеток на литр крови;
- 6-16 лет — 0,8-8*109 клеток на литр крови;
- старше 16 – 0,8-4*109 клеток на литр крови.
Повышение лимфоцитов отмечается тогда, когда полученные показатели близки к верхней границе (немного повышены), или превышают это показатель.
Степень превышения рекомендованных стандартов указывает на опасность состояния для здоровья человека.
Повышенные лимфоциты могут свидетельствовать о различных состояниях организма, и врачи подчеркивают важность их правильной интерпретации. Лимфоциты — это ключевые элементы иммунной системы, и их увеличение часто связано с инфекциями, воспалительными процессами или даже аутоиммунными заболеваниями. Врачи отмечают, что временное повышение лимфоцитов может быть нормальной реакцией на вирусные инфекции, такие как грипп или простуда. Однако, если уровень лимфоцитов остается высоким длительное время, это может потребовать более тщательного обследования для исключения серьезных заболеваний, таких как лимфома или хронические инфекции. Специалисты рекомендуют не игнорировать результаты анализов и обращаться за консультацией к врачу, чтобы определить причину изменений и получить соответствующее лечение.

Каким анализом определяется?
Для определения количественного и качественного состава лимфоцитов используют общий анализ крови, забор которой осуществляют из пальца. Далее кровь рассматривается под микроскопом, где видны все ее фракции. Выделенные лимфоциты подсчитываются, при этом учитывается степень их зрелости, объемы и другие индивидуальные показатели.
Манипуляция может осуществляться как вручную с использованием микроскопа, так и с помощью современных аппаратов, способных автоматизировать данный процесс.
Разновидности лимфоцитоза
Абсолютный лимфоцитоз диагностируется в том случае, когда количество иммунных клеток превышает норму, установленную для определенного возраста. В данном случае высокие лимфоциты для взрослого пациента будут превышать показатель в 4*109.
Относительный лимфоцитоз наблюдается тогда, когда общее количество лейкоцитов снижается в сторону нейтрофилов, при этом лимфоцитов по процентному соотношению получается больше. Но абсолютные показатели в данном случае находятся в пределах нормы.
Увеличение процентного содержания лимфоцитов принято рассматривать как лейкопению.
Повышенные лимфоциты — это тема, которая вызывает много обсуждений среди людей, особенно когда речь идет о здоровье. Многие отмечают, что увеличение уровня лимфоцитов может свидетельствовать о наличии инфекции или воспалительного процесса в организме. Некоторые делятся своим опытом, когда после анализа крови им ставили диагноз, связанный с вирусными заболеваниями, такими как грипп или COVID-19.
Другие же говорят о том, что повышенные лимфоциты могут быть следствием стресса или аллергических реакций. Важно отметить, что не всегда это состояние требует немедленного вмешательства. Многие врачи рекомендуют повторные анализы и наблюдение за состоянием пациента.
Люди также обсуждают, как образ жизни и питание могут влиять на уровень лимфоцитов. Здоровое питание, физическая активность и отказ от вредных привычек часто упоминаются как способы поддержания нормального уровня лимфоцитов. В целом, эта тема вызывает интерес и порождает множество вопросов о здоровье и профилактике заболеваний.

Что может повлиять на результаты анализа?
В медицинской практике нет определенных факторов, которые могут кардинально изменить картину, если повышены лимфоциты. Однако незначительные колебания могут быть спровоцированы соблюдением строгой диеты, сильными физическими нагрузками, а также постоянными стрессами. Поэтому перед сдачей анализа желательно хорошо выспаться и отдохнуть.
Симптомы и признаки

- Увеличение лимфоузлов в области шеи и в подмышечных впадинах.
- Кашель без видимых причин, насморк и боль в горле, что схоже с проявлением простуды.
- Сильные головные боли, которые не могут самоустраняться.
- Увеличение температуры тела, появление озноба и холодного пота.
- Проблемы с пищеварительным трактом: запоры и поносы, рвоты, отсутствие аппетита.
- Мышечные боли в области спины.
- Бессонница и истощение организма.
Важно отметить, что высокая температура может расти до критических показателей, при этом жаропонижающие медикаменты не дают эффекта.
Лимфоузлы, которые выступают в роли депо для лимфоцитов, стремительно увеличиваются в размерах, становятся более плотными.
Подобная симптоматика должна быть немедленно показана специалисту. Вовремя поставленный диагноз и поиск первопричины развития лимфоцитоза, увеличивает шансы на выздоровление, а также снижает риски для организма.

Опасности и последствия
Главная опасность, которую хранит в себе повышенный уровень лимфоцитов – это наличие первопричины. Важно знать, что стремительное увеличение численности иммунных клеток не развивается на ровном месте. Для этого всегда существуют предпосылки. Не всегда врачи обращают внимание на анализы крови, занимаясь лечением обычной простуды. Хотя на самом деле боль в горле и кашель могут выступать в роли симптоматики прогрессирующего лимфоцитоза, причиной развития которого послужило диаметрально противоположное заболевание.
Если повышенное содержание лимфоцитов длительное время оставлять без внимания и списывать на особенности организма (особенно это касается детей), то в итоге могут развиваться такие неприятные последствия, как:
- Появление хронических заболеваний воспалительного характера, которые невозможно полностью вылечить в силу проблем с иммунитетом.
- Развитие критически низкого иммунитета, что спровоцирует частые болезни, сделав из организма крепость с открытыми воротами, через которые патогенные микроорганизмы способны беспрепятственно проникать и приносить вред здоровью.
- Поражение лимфатической системы и развитие патологий, несовместимых с жизнью.
- Патологии костного мозга, в том числе рак крови.
Как видно, превышение лимфоцитов может быть крайне опасным для здоровья, поэтому любые отклонения от нормы не должны быть оставлены без внимания.
Поиск первопричины позволит избежать усугубления ситуации, а также своевременно выявить начальные стадии развития серьезного недуга.
Причины повышения

- вирусные инфекции;
- инфекции бактериального типа;
- паразитарные инфекции;
- воздействие стресса и курения;
- патологии кроветворительной функции;
- длительное использование медикаментов, способных влиять на количественный и качественный состав крови.
Инфекции, возбудителями которых является вирус, провоцируют высокий уровень лимфоцитов, что по факту является естественным процессом.
Но далеко не все инфекционные заболевания способны проходить для организма бесследно. Некоторые болезни оказывают повышенное воздействие на лимфатическую систему, в результате чего наблюдаются повышенные лимфоциты в крови. Самыми опасными из них являются:
- корь;
- ротавирус;
- СПИД;
- дифтерия;
- краснуха;
- полиомиелит;
- сифилис.
Чаще всего развивается относительный лимфоцитоз, при котором увеличивается численность лейкоцитов в общем объеме крови.

Инфекции бактериального типа вызывают постепенное увеличение показателей, а процент лимфоцитов растет намного медленнее, нежели при наличии вируса. Так же как и в первом случае, высокие показатели свидетельствуют об активизации иммунитета. Сопровождаются постепенным увеличением температуры тела, но не более 39̊С. Наиболее распространенными из них являются:
- менингит;
- брюшной тиф;
- пневмония;
- туляремия.
Люди, которые довольно тесно контактируют с животными, могут заработать лимфоцитоз, вызванный паразитарными инфекциями.
Одной царапины кошки или незначительного укуса морской свинки бывает достаточно, чтобы заразиться и искать причину, почему повышены лимфоциты. Главная опасность паразитарного инфицирования в том, что симптоматика достаточно длительное время остается малоинформативной. Однако, когда иммунные клетки не могут контролировать процесс размножения паразитарных клеток, клиническая картина стремительно развивается. Поднимается температура, а также ухудшается общее состояние организма.
Самыми опасными и коварными инфекциями, вызванными паразитами, являются:
- токсокароз;
- аскаридоз;
- лямблиоз.
Несмотря на то, что весь мир постепенно отказывается от курения, для многих людей среднего возраста понятия «сигарета» и «стресс» равны между собой.
И количество первого прямопропорционально увеличению второго. Никотин и вредные смолы способны проникать в кровь и провоцировать интоксикацию, реакция на которую и проявляется в виде лимфоцитоза. В случае, когда курение является постоянной привычкой, а объемы потребляемого никотина постоянно растут, речь идет о хроническом лимфоцитозе, который оказывает повышенную нагрузку, как на иммунитет, так и на общее состояние здоровья в целом.
Также причиной высоких показателей могут стать появления таких заболеваний как лейкоз и лимфома. В большинстве случае это провоцирует онкологию, борьба с которой невероятно сложная. Самыми сложными в плане терапии и опасными в плане низкой выживаемости считаются такие болезни системы кроветворения, как:
- лимфосаркома;
- лимфобластный лейкоз;
- лимфома;
- лимфогранулематоз.
Некоторые медикаменты способны провоцировать повышенный синтез лейкоцитов.
К ним относят:
- анальгетики опиоидной группы;
- антибиотики циклоспоринового ряда и ураны;
- Фенитоин и Леводопа.
В данном случае показатели выравняются, как только прием этих лекарств будет прекращен.
Существует такое понятие, как постинфекционный лимфоцитоз, когда высокие показатели могут сохраняться после выздоровления еще 1-2 недели. Данный процесс является естественным, поскольку выработка и утилизация лейкоцитарных клеток не может производиться в один миг.
Требуется определенное время, чтобы все показатели крови пришли в норму.
Также провоцировать повышенное содержание лимфоцитов различных типов в крови, могут такие факторы, как:
- недостаток витамина В12;
- вакцинация;
- удаление селезенки или ее части;
- чрезмерные физические нагрузки, ведущие к истощению организма;
- наличие аллергических реакций, при которых Т-лимфоциты повышены, а остальные фракции находятся в пределах нормы;
- неправильное питание, в котором преобладают углеводы;
- хронический алкоголизм, который провоцирует увеличение не только лимфоцитов, но и сгущение крови, что затрудняет ее прохождение по сосудам;
- предменструальный синдром, сопровождающийся резкими изменениями уровня половых гормонов;
- длительное голодание и отсутствие нужного количества жидкости в организме;
- отравление вредными токсичными веществами;
- наличие ранних стадий онкологических заболеваний, при которых лимфоциты повышены у взрослого в общем объеме, а у ребенка – в количественном.
Аутоиммунные заболевания, особенно в стадии активного прогрессирования, также способны провоцировать лимфоцитоз, при котором в крови повышены относительные лимфоциты.
Сюда относят болезнь Крона, системную красную волчанку, ревматоидный артрит.
Что предпринять?
В случае, когда анализ крови показал, что повышены лимфоциты (относительные и абсолютные показатели) у взрослого или ребенка. Важно максимально быстро установить причину. Для этого необходимо обратиться к участковому терапевту или педиатру, после чего пройти полное обследование. Причины могут быть самыми разнообразными, но именно от диагноза будет зависеть дальнейшая терапия состояния. Как понизить лимфоциты, подскажет только доктор. Не стоит заниматься самолечением, особенно используя рецепты нетрадиционной медицины, которые не имеют официального подтверждения эффективности.
Категорически запрещено самостоятельно принимать препараты, способные влиять на количественный и качественный состав лейкоцитов.
Это может быть опасно для жизни и здоровья, а также спровоцировать массу побочных реакций, в том числе и летальный исход.
Какие медикаменты могут назначить?
Повышенные в крови лимфоциты нормализуются тогда, когда будет устранена причина. Терапия основывается на симптоматическом лечении, а также комплексном лечении, которое подбирается в соответствии с типом заболевания.
В случае, когда доктор установил, что причиной высоких показателей в анализе крови лимфоцитов (Lym) являются вирусные инфекции, подбираются медикаменты с противовирусным эффектом. Чаще всего используют:




Если причиной того, что отмечается повышенный уровень лимфоцитов в процентном соотношении в крови, являются инфекции, грибы или паразиты, назначают антибактериальную и протипротозойную терапию.
Самыми эффективными антибиотиками, которые имеют широкий спектр воздействия, являются:



В случае развития аллергической реакции, за возникновение которой отвечают лимфоциты, назначают антигистаминную терапию, вводя в организм противоаллергические препараты: Диазолин, Супрастин, Фенистил. Когда аллергия затягивается и сопровождается анафилактическим шоком, при котором в крови рекордно повышены лимфоциты, требуется реанимация с введением адреналина и глюкокортикостероидов.
Когда повышены лимфоциты в крови, но что это значит и какова причина нет времени разбираться, могут использоваться медикаменты, способные корректировать уровень лейкоцитарных клеток в крови и останавливать их дальнейший синтез клетками костного мозга.
Такая экстренная терапия используется в крайних случаях, когда над человеком нависает угроза летального исхода.
Корректирующая диета

- Режим – пищу принимают не менее 6 раз в день, маленькими порциями, что поможет ускорить обменные процессы, а также снизить нагрузку на пищеварительный тракт.
- Способ термической обработки – мясо и рыбу используют только нежирных сортов, а при приготовлении не используют растительные и животные жиры. Отдают предпочтение тушению, запеканию, варке.
- Сочетание БЖУ – завтрак должен состоять преимущественно из сложных углеводов, на обед употребляют углеводы, белки и жиры, а в ужине должны преобладать белки. Это поможет сделать рацион более правильным, наладив все обменные процессы.
- Подсчет калорий – дневной каллораж не должен превышать 1500 кКал, чего вполне достаточно при наличии лимфоцитоза.
- Овощи и фрукты в свежем виде помогают восполнить дефицит витаминов, а также укрепить иммунитет.
Немаловажно пить много жидкости.
Помимо травяных чаев нужно выпивать в день минимум 1,5 л чистой воды без газа, что позволит сделать кровь менее густой, а также ускорить ее прохождение в кровеносной системе.
Следует отказаться от приема таких продуктов, как:
- сладкие кондитерские изделия и газированные напитки;
- копчености и колбасы, сало и буженина, жирные сорта мяса;
- консервы и соленья, провоцирующие задержку солей в организме;
- хлебобулочные изделия.
Соблюдение диеты позволит снизить нагрузку на организм, а также способствует скорейшей нормализации показателей.
Другие методы
В случае диагностирования высоких показателей пациенту рекомендуют кардинально изменить образ жизни, отказавшись, в первую очередь от вредных привычек. Именно алкоголь и курение способствуют снижению иммунитета, а также вызывает повышенную нагрузку на весь организм. Помимо диеты больному рекомендуют:
- бывать на свежем воздухе не менее 2 часов в день;
- ограничить физические нагрузки или на время лечения полностью отказаться от них;
- соблюдение всех рекомендаций врача, а также отказ от самолечения и использования нетрадиционной медицины;
- ограничение контактов с людьми, имеющими хронические заболевания вирусного или бактериального характера;
- соблюдение правил гигиены.
После того, как выявлена первопричина увеличения этих клеток, важно подобрать комплексное лечение.
Но что делать. Если показатели критичные и угрожают жизни, а времени на диагностику нет? Может использоваться такая процедура, как переливание крови. Для этого у пациента производят забор крови (300-450 мл), пропускают ее через специальный аппарат, который может улавливать, задерживать и сепарировать лимфоциты. Полученную очищенную кровь вводят обратно. Данную процедуру производят строго по показаниям, особенно, если речь идет о наличии онкологического заболевания.
Профилактика повышения
Для того, чтобы предупредить развитие лимфоцитоза, необходимо придерживаться следующих рекомендаций:
- Вести активный образ жизни, уделяя внимание питанию. Пить больше жидкости, а также отказаться от вредных привычек.
- Любые физические нагрузки дозировать, дабы не спровоцировать физическую усталость.
- Ограничить контакт с высокотоксичными веществами.
- Следить за состоянием гормональной системы, а также за весом тела, изменение которого может указывать о наличии проблем со здоровьем.
- Минимум 2 раза в год сдавать кровь на анализ, что помогает выявить наличие лимфоцитоза на ранних стадиях, а также подобрать правильную терапию.
Только соблюдение всех вышеуказанных рекомендаций способствует снижению риска развития высокого уровня лимфоцитов.
Рекомендуем посмотреть полезное видео
Таким образом, становится понятным, если лимфоциты повышены у взрослого или ребенка, о чем это говорит. Наличие лимфоцитоза должно контролироваться специалистом, так как причины его развития могут быть самыми непредсказуемыми. Комплексное обследование позволит определить, почему эта фракция крови повышена, и как это устранить с минимальным ущербом для здоровья. Не стоит игнорировать данный показатель в анализе крови, списывая все на особенности иммунной системы. Ранняя диагностика способствует снижению риска развития онкологических заболеваний.
Вопрос-ответ
Что такое лимфоциты и какую роль они играют в организме?
Лимфоциты — это тип белых кровяных клеток, которые играют ключевую роль в иммунной системе. Они помогают организму бороться с инфекциями, распознавая и уничтожая патогенные микроорганизмы, такие как вирусы и бактерии. Лимфоциты делятся на несколько подтипов, включая Т-лимфоциты, которые атакуют инфицированные клетки, и В-лимфоциты, которые производят антитела для нейтрализации патогенов.
Какие причины могут привести к повышению уровня лимфоцитов в крови?
Повышение уровня лимфоцитов, известное как лимфоцитоз, может быть вызвано различными факторами, включая вирусные инфекции (например, грипп или мононуклеоз), хронические воспалительные заболевания, аллергические реакции, а также некоторые виды рака, такие как лимфома. Важно провести дополнительные исследования для определения точной причины лимфоцитоза.
Каковы симптомы, связанные с повышенным уровнем лимфоцитов?
Повышенный уровень лимфоцитов сам по себе не всегда вызывает симптомы. Однако, если лимфоцитоз вызван инфекцией или заболеванием, могут наблюдаться такие симптомы, как усталость, лихорадка, потливость, увеличение лимфатических узлов или боли в горле. Важно обратиться к врачу для диагностики и лечения, если возникают такие симптомы.
Советы
СОВЕТ №1
Регулярно проходите медицинские обследования, чтобы контролировать уровень лимфоцитов. Это поможет выявить возможные проблемы на ранней стадии и своевременно обратиться к врачу.
СОВЕТ №2
Обратите внимание на свое питание. Употребление продуктов, богатых витаминами и минералами, таких как фрукты, овощи и орехи, может поддерживать иммунную систему и способствовать нормализации уровня лимфоцитов.
СОВЕТ №3
Управляйте стрессом с помощью методов релаксации, таких как медитация, йога или прогулки на свежем воздухе. Хронический стресс может негативно влиять на иммунную систему и уровень лимфоцитов.
СОВЕТ №4
Если у вас повышены лимфоциты, обсудите с врачом возможные причины и методы лечения. Не занимайтесь самолечением и следуйте рекомендациям специалиста для достижения наилучших результатов.

